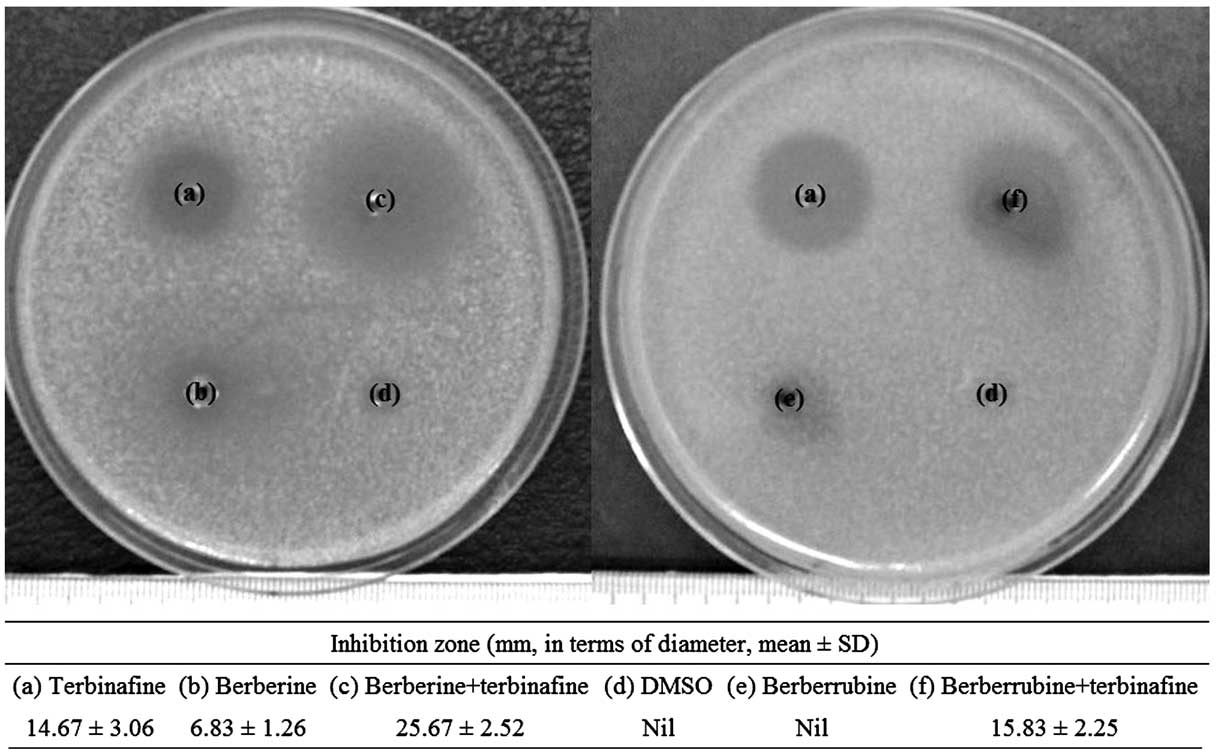

Introduction
The incidence of Candida infections has increased in
patients who receive immunosuppressive therapy, cancer chemotherapy
and transplantation. Among the Candida species, Candida
albicans (C. albicans) is responsible for 50–70% of
cases of invasive candidiasis in the majority of clinical settings
(1,2).
C. albicans, an opportunistic fungal pathogen that normally
inhabits the mucous membranes of the gastrointestinal and female
genital tracts (3), is able to attack
the immunocompromised patients (4).
When the normal microbial barrier is disrupted, C. albicans
can invade the intestinal and female genital mucosal barriers and
causes candidiasis and candidemia (5,6). A
cross-sectional study has reported that Candida species
isolation from the vaginal mucosa was more frequent in human
immunodeficiency virus (HIV)-infected patients (29.7%) when
compared with uninfected women (14.5%). C. albicans was the
most prevalent pathogen isolated in HIV-infected (52.9%) and
uninfected women (85.7%) (7). A
previous study investigated 128 Candida isolates from South
Africa and 126 Cameroonian Candida isolates. Of those, C.
albicans was responsible for the highest percentage of them,
with 82.8% of South African isolates and 73.0% of the Cameroonian
isolates (8). In another study, of the
103 Candida species-infected oral mucosal isolates
identified in HIV patients, C. albicans accounted for the
majority of Candida species (77.7%) (9). A prospective observational study also
examined the occurrence of oral Candida colonization among cancer
patients in China between October 2012 and March 2013. C.
albicans was the most common species isolated from patients,
accounting for 30.8% in patients with pulmonary cancer (n=78),
33.7% in patients with digestive tract malignant tumor (n=101), and
12.7% in patients with hematopoietic system tumor (n=79). Cancer
patients are a high-risk population for Candida colonization
(10).
Traditional Chinese medicines (TCMs) remain a
fundamental role in the treatment of various diseases due to their
long history of clinical practice and reliable therapeutic
efficacy. Berberine (Fig. 1A) is an
isoquinoline quaternary alkaloid isolated from the traditional
Chinese herb, Coptidis Rhizoma (also known as Huanglian),
which includes several species: Coptis chinensis French,
Coptis deltoidea and Coptis teetoides (11,12).
Berberrubine (Fig. 1B) is isolated
from the medicinal plant Berberis vulgaris (13), but is also readily derived from
berberine by pyrolysis (14). Kim
et al (15) studied the
antimicrobial activity of berberine, berberrubine,
9-O-acylberberrubines and 9-O-alkylberberrubines.
Berberrubine exhibited a relatively weaker anti-C. albicans
activity [minimum inhibitory concentration (MIC) >128 µg/ml]
than berberine (MIC = 128 µg/ml), while some of the acyl
derivatives (decanoyl and lauroyl berberrubine chlorides) and the
alkyl derivatives (heptyl, octyl, nonyl, decyl and undecyl) showed
much stronger growth inhibition against C. albicans, with
the MICs ranging from 1–4 µg/ml. Park et al (16) reported the antifungal activity of
13-(substituted benzyl) berberine and berberrubine derivatives.
Among them, 13-(4-tertbutylbenzyl) and 13-(4-isopropyl benzyl)
berberine derivatives exhibited the strongest antifungal activity
against C. albicans (MICs = 4 µg/ml) when compared with
berberine (MIC = 128 µg/ml). The 13-(4-tertbutylbenzyl) and
13-(4-isopropyl benzyl) berberrubines showed a better anti-C.
albicans activity (MICs = 16 µg/ml) when compared with
berberrubine (MIC >128 µg/ml).
TCMs can be used as complementary medicines to
conventional drugs for a variety of disease treatments. Our
previous study reported the complementary use of corilagin, a
gallotannin identified in numerous plants, including Phyllanthus
urinaria, with two chemotherapeutic drugs, cisplatin and
doxorubicin, in order to lower the working concentration of these
two agents and to obtain an increment in the anticancer effect. The
IC50 values were ~3-fold reduced for cisplatin and
~4-fold decreased for doxorubicin with the Hep3B hepatoma cells in
the presence of corilagin (17). The
efficacy of standard antibiotics against bacterial strains was
improved by the use of plant materials (18–21). TCMs as
a complementary therapy with the standard antifungal drugs against
fungal pathogens have emerged as a new choice for the treatment of
infectious diseases. The present study utilizes the TCMs, berberine
and berberrubine, as complementary agents with the standard
antifungal drug, terbinafine, against the most common
Candida species, C. albicans, responsible for the
increased incidence of fungal infections.
Materials and methods
Chemical analysis
Nuclear magnetic resonance (NMR) spectra were
recorded on a Bruker/Varian 500 MHz Fourier transform spectrometer
(Agilent Technologies, Santa Clara, CA, USA). 1H and 13C-NMR
spectra were recorded relative to residual protiated solvent; a
positive value of the chemical shift denoted a resonance downfield
from tetramethylsilane (TMS, internal standard). J-values
were in Hz. All the chemicals were purchased from commercial
suppliers and used without further purification. All the reactions
were monitored by analytical thin-layer chromatography (TLC) on
Merck aluminum-precoated plates of silica gel 60 F254 with
detection by spraying with 5% (w/v) dodecamolybdophosphoric acid in
ethanol or 5% (w/v) ninhydrin in ethanol and subsequent
heating.
Synthesis of natural berberrubine
Natural berberrubine was synthesized according to
the reported procedure (22).
Berberine chloride (2.01 g, 5.4 mmol) was heated at 190°C under
reduced pressure for 2 h and the crude product was recrystallized
from chloroform and hexane to obtain the title berberrubine in 83%
yield as a dark red precipitate: Rf=0.29
(dichloromethane-methanol, 15:1); 1H-NMR (CDCl3) d9.20
(s, 1H), 7.58 (s, 1H), 7.30–7.24 (m, 2H), 6.75 (s, 1H), 6.51–6.49
(m, 1H), 6.06 (s, 2H), 4.42 (s, 2H), 3.89 (s, 3H), 3.09 (s, 2H);
13C-NMR (CDCl3) d167.7, 150.3, 149.1, 148.2, 145.9,
133.1, 131.5, 128.3, 122.2, 120.7, 120.2, 117.7, 108.4, 104.6,
103.3, 101.9, 56.2, 53.4, 28.6.
Determination of MIC and minimum
fungicidal concentration (MFC)
C. albicans was obtained from American Type
of Culture Collection (Manassas, VA, USA). The MIC values of
berberine, berberrubine (kindly provided by Professor K.K.H. Lee)
and terbinafine (both from Sigma-Aldrich, St. Louis, MO, USA) on
C. albicans were determined by the broth dilution method.
Briefly, different concentrations of berberine, berberrubine and
terbinafine were loaded from a starting concentration of 100 µg/ml
containing 1% dimethylsulfoxide (DMSO) as the vehicle and they were
diluted serially. DMSO (1%) was used as a vehicle control. The
fungal samples were subsequently incubated at 35°C for 48 h. The
minimum concentrations of berberine, berberrubine and terbinafine,
which induced a complete growth inhibition would be recorded as
their MIC values (16,23). For the determination of MFC, 10 µl of
the 48 h incubated medium was removed and plated. MFC was recorded
at a concentration where no colony of fungal growth was observed.
When MFC/MIC <4, the compound or combination would be considered
as fungicidal, while when MFC/MIC ≥4 the compound or combination
would be considered as fungistatic. In each case, three independent
experiments were conducted and each experiment was carried out in
triplicates.
Sensitization test
For the sensitization investigation experiment, the
(3-(4,5-dimethylthiazol-2-yl)-5-(3-carboxymethoxy-phenyl)-2-(4-sulfophenyl)-2H-tetrazolium)
(MTS) assay was employed (24).
Briefly, C. albican cells were seeded at day 0 in the
96-well microplate. Terbinafine was added at 25, 12.5, 6.25, 3.13,
1.56, 0.78, 0.39 and 0.2 µg/ml, respectively, while berberine and
berberrubine were added at 100 µg/ml together with terbinafine.
After 48 h of incubation, MTS (Promega, Madison, WI, USA)/phenazine
methosulfate (PMS) as electron coupling agent mixed solution was
added. Lastly, optical absorbance was determined at 490 nm using a
microplate reader (Perkin Elmer Victor V) according to the
manufacturer's protocol. To determine MIC and MFC values from the
sensitization test, no MTS/PMS was added and the experimental
procedures were conducted as mentioned before. In each case, three
independent experiments were conducted and each experiment was
carried out in triplicates.
Zone of inhibition study
C. albicans was used to study the
effectiveness of berberine alone (100 µg), berberine (100 µg) plus
terbinafine (6 µg), berberrubine alone (100 µg), and berberrubine
(100 µg) plus terbinafine (6 µg) against its growth in culture.
C. albicans was diluted with yeast mold broth and plated on
the yeast mold agar plate, and the holes were created on the agar
using a sterile transfer pipette. For the tested samples, 1% DMSO
(as negative control) and 6 µg terbinafine (as positive control)
were placed in the holes of agar. The plates were subsequently
incubated at 35°C for 48 h and the inhibition zones (mm, in terms
of diameter) of fungi on the agar plates were recorded (23,25,26).
Results and Discussion
Determination of MIC, MFC and
sensitization assay
Terbinafine is an allylamine agent with a broad
spectrum of antifungal activity. It interferes with the
biosynthesis of ergosterol, an essential component of fungal cell
membranes, via inhibition of the fungal enzyme squalene epoxidase.
In the in vitro susceptibility tests, terbinafine have been
shown to possess primarily fungicidal activity against
dermatophytes, moulds and certain dimorphic fungi, but only
fungistatic activity against C. albicans (27). The cell death mechanisms of berberine
against C. albicans have been fully addressed in the
previous studies. They involved the ability to impair mitochondrial
function, generation of reactive oxygen species, targeting cell
wall integrity pathway and also affecting heat shock transcription
factor, HSF1 (28). The MIC and MFC
values of terbinafine against C. albicans were determined as
6 and 24 µg/ml, respectively. As MFC/MIC was equal to 4, it was
considered to be fungistatic. For berberine and berberrubine, their
MIC values were >100 µg/ml. No MFC value was determined. These
findings were consistent with the results reported previously
(16). However, berberine and
berberrubine at 100 µg/ml could not improve the MFC, and the MFC of
terbinafine could significantly potentiate the antifungal activity
of terbinafine on C. albicans as determined by the MTS/PMS
assay. Berberine and berberrubine at 100 µg/ml could effectively
assist the antifungal potential of terbinafine (Fig. 2). Notably, the complementary activity
of berebrine with terbinafine was much stronger than that of
berberrubine when terbinafine was loaded from 3.13, 1.56, 0.78,
0.39 and 0.2 µg/ml. Therefore, berberine was more effective in
amplifying the antifungal action of terbinafine when compared with
its analogue, berberrubine.
Zone of inhibition study
Previous studies have reported that berberine in
combination with fluconazole or miconazole showed a synergistic
antifungal activity against C. albicans with larger
inhibition zones in the agar diffusion tests (29–31). In
order to evaluate the sensitivity of C. albicans to the
combination of terbinafine and berberine or berberrubine, agar
diffusion assays were conducted to determine their inhibition zones
on the agar plates. Terbinafine alone at 6 µg possessed certain
fungistatic effect against C. albicans (inhibition zone,
14.67±3.06 mm), whereas berberine or berberrubine alone showed
small or no level of growth inhibition of the fungi (Fig. 3). The combination of 100 µg berberine
and 6 µg terbinafine showed an increased inhibition zones in size
(inhibition zone, 25.67±2.52 mm) when compared with terbinafine
alone. The result may suggest that a synergistic fungistatic
activity against C. albicans may occur between the combined
drugs even if the MIC and MFC of this combination were not
improved. However, the combination of 100 µg berberrubine and 6 µg
terbinafine did not enhance the fungal sensitivity, with no
significant enlargement in size of inhibition zone. No growth
inhibition of C. albicans could be found in 1% DMSO (vehicle
control).
In conclusion, the present study reports the
complementary application of berberine and berberrubine with
terbinafine against the opportunistic fungal pathogen, C.
albicans. A recent study has demonstrated that berebrine can
assist fluconazole to kill fluconazole-resistant C. albicans
(32). The present results further
indicate the possible sensitization of various pathogenic fungi to
other standard drugs by berberine and berberrubine, with the
purpose of obtaining an increment in the antifungal potency.
Acknowledgements
The present study was supported by the Innovation
Technology Commission to ABCT and HKPU [with the grant codes
FRG/14-15/021, 30-14-121 and 38-40-116 (Dr C.H.C.)], as well as
grant no. 03-16-176 (Professor Z.X.B.). Professor R.G. received a
grant from AIRC (contract no. IG 13575).
References
|
1
|
Sanguinetti M, Posteraro B and Lass-Flörl
C: Antifungal drug resistance among Candida species:
Mechanisms and clinical impact. Mycoses. 58(Suppl 2): 2–13. 2015.
View Article : Google Scholar : PubMed/NCBI
|
|
2
|
Arendrup MC: Epidemiology of invasive
candidiasis. Curr Opin Crit Care. 16:445–452. 2010. View Article : Google Scholar : PubMed/NCBI
|
|
3
|
Richards MJ, Edwards JR, Culver DH and
Gaynes RP: National Nosocomial Infections Surveillance System:
Nosocomial infections in coronary care units in the United States.
Am J Cardiol. 82:789–793. 1998. View Article : Google Scholar : PubMed/NCBI
|
|
4
|
Pu Y, Liu A, Zheng Y and Ye B: In vitro
damage of Candida albicans biofilms by chitosan. Exp Ther
Med. 8:929–934. 2014.PubMed/NCBI
|
|
5
|
Schulze J and Sonnenborn U: Yeasts in the
gut: From commensals to infectious agents. Dtsch Arztebl Int.
106:837–842. 2009.PubMed/NCBI
|
|
6
|
Nenoff P, Krüger C, Schaller J,
Ginter-Hanselmayer G, Schulte-Beerbühl R and Tietz HJ: Mycology -
an update part 2: dermatomycoses: clinical picture and diagnostics.
J Dtsch Dermatol Ges. 12:749–777. 2014. View Article : Google Scholar : PubMed/NCBI
|
|
7
|
Oliveira PM, Mascarenhas RE, Lacroix C,
Ferrer SR, Oliveira RP, Cravo EA, Alves AP and Grassi MF:
Candida species isolated from the vaginal mucosa of
HIV-infected women in Salvador, Bahia, Brazil. Braz J Infect Dis.
15:239–244. 2011. View Article : Google Scholar : PubMed/NCBI
|
|
8
|
Dos Santos, Abrantes PM, McArthur CP and
Africa CW: Multi-drug resistant oral Candida species
isolated from HIV-positive patients in South Africa and Cameroon.
Diagn Microbiol Infect Dis. 79:222–227. 2014. View Article : Google Scholar : PubMed/NCBI
|
|
9
|
Ribeiro RAL, de Alencar Menezes TO, de
Melo Alves-Junior S, de Menezes SA, Marques-da-Silva SH and Rosário
Vallinoto AC: Oral carriage of Candida species in
HIV-infected patients during highly active antiretroviral therapy
(HAART) in Belém, Brazil. Oral Surg Oral Med Oral Pathol Oral
Radiol. 120:29–33. 2015. View Article : Google Scholar : PubMed/NCBI
|
|
10
|
Sun H, Chen Y, Zou X, Li H, Yin X, Qin H,
Liu R, Yu C, Li Q, Yu K, et al: Occurrence of oral Candida
colonization and its risk factors among patients with malignancies
in China. Clin Oral Investig. Jul 30–2015.(Epub ahead of print).
PubMed/NCBI
|
|
11
|
Tang J, Feng Y, Tsao S, Wang N, Curtain R
and Wang Y: Berberine and Coptidis rhizoma as novel
antineoplastic agents: A review of traditional use and biomedical
investigations. J Ethnopharmacol. 126:5–17. 2009. View Article : Google Scholar : PubMed/NCBI
|
|
12
|
Liu R, Zhang X, Zhang L, Gao X, Li H, Shi
J and Li X: Bitterness intensity prediction of berberine
hydrochloride using an electronic tongue and a GA-BP neural
network. Exp Ther Med. 7:1696–1702. 2014.PubMed/NCBI
|
|
13
|
Kobayashi Y, Yamashita Y, Fujii N,
Takaboshi K, Kawakami T, Kawamura M, Mizukami T and Nakano H:
Inhibitors of DNA topoisomerase I and II isolated from the Coptis
rhizomes. Planta Med. 61:414–418. 1995. View Article : Google Scholar : PubMed/NCBI
|
|
14
|
Iwasa K, Kamigauchi M, Ueki M and
Taniguchi M: Antibacterial activity and structure-activity
relationships of berberine analogs. Eur J Med Chem. 31:469–478.
1996. View Article : Google Scholar
|
|
15
|
Kim SH, Lee SJ, Lee JH, Sun WS and Kim JH:
Antimicrobial activity of 9-O-acyl- and 9-O-alkylberberrubine
derivatives. Planta Med. 68:277–281. 2002. View Article : Google Scholar : PubMed/NCBI
|
|
16
|
Park KD, Lee JH, Kim SH, Kang TH, Moon JS
and Kim SU: Synthesis of 13-(substituted benzyl) berberine and
berberrubine derivatives as antifungal agents. Bioorg Med Chem
Lett. 16:3913–3916. 2006. View Article : Google Scholar : PubMed/NCBI
|
|
17
|
Gambari R, Hau DK, Wong WY and Chui CH:
Sensitization of Hep3B hepatoma cells to cisplatin and doxorubicin
by corilagin. Phytother Res. 28:781–783. 2014. View Article : Google Scholar : PubMed/NCBI
|
|
18
|
Darwish RM, Aburjai T, Al-Khalil S and
Mahafzah A: Screening of antibiotic resistant inhibitors from local
plant materials against two different strains of Staphylococcus
aureus. J Ethnopharmacol. 79:359–364. 2002. View Article : Google Scholar : PubMed/NCBI
|
|
19
|
Yang ZC, Wang BC, Yang XS, Wang Q and Ran
L: The synergistic activity of antibiotics combined with eight
traditional Chinese medicines against two different strains of
Staphylococcus aureus. Colloids Surf B Biointerfaces.
41:79–81. 2005. View Article : Google Scholar : PubMed/NCBI
|
|
20
|
Mandal S, DebMandal M, Pal NK and Saha K:
DebMandal M, Pal NK and Saha K: Synergistic anti-Staphylococcus
aureus activity of amoxicillin in combination with Emblica
officinalis and Nymphae odorata extracts. Asian Pac J
Trop Dis. 3:711–714. 2010. View Article : Google Scholar
|
|
21
|
Mandal S, Mandal MD and Pal NK: Enhancing
chloramphenicol and trimethoprim in vitro activity by Ocimum
sanctum Linn. (Lamiaceae) leaf extract against
Salmonella enterica serovar Typhi. Asian Pac J Trop Med.
5:220–224. 2012. View Article : Google Scholar : PubMed/NCBI
|
|
22
|
Bodiwala HS, Sabde S, Mitra D, Bhutani KK
and Singh IP: Synthesis of 9-substituted derivatives of berberine
as anti-HIV agents. Eur J Med Chem. 46:1045–1049. 2011. View Article : Google Scholar : PubMed/NCBI
|
|
23
|
NCCLS. Reference Method for Broth Dilution
Antifungal Susceptibility Testing of Yeasts; Approved Standard
(2nd). National Committee for Clinical Laboratory Standards.
(Wayne, PA). M27-A2:2002.
|
|
24
|
Zhu J, Krom BP, Sanglard D, Intapa C,
Dawson CC, Peters BM, Shirtliff ME and Jabra-Rizk MA:
Farnesol-induced apoptosis in Candida albicans is mediated
by Cdr1-p extrusion and depletion of intracellular glutathione.
PLoS One. 6:e288302011. View Article : Google Scholar : PubMed/NCBI
|
|
25
|
Chung PY, Gambari R, Chen YX, Cheng CH,
Bian ZX, Chan AS, Tang JC, Leung PH, Chui CH and Lam KH:
Development of 8-benzyloxy-substituted quinoline ethers and
evaluation of their antimicrobial activities. Med Chem Res.
24:1568–1577. 2015. View Article : Google Scholar
|
|
26
|
Lam PL, Gambari R, Kok SH, Lam KH, Tang
JC, Bian ZX, Lee KK and Chui CH: Non-toxic agarose/gelatin-based
microencapsulation system containing gallic acid for antifungal
application. Int J Mol Med. 35:503–510. 2015.PubMed/NCBI
|
|
27
|
McClellan KJ, Wiseman LR and Markham A:
Terbinafine. An update of its use in superficial mycoses. Drugs.
58:179–202. 1999. View Article : Google Scholar : PubMed/NCBI
|
|
28
|
Dhamgaye S, Devaux F, Vandeputte P,
Khandelwal NK, Sanglard D, Mukhopadhyay G and Prasad R: Molecular
mechanisms of action of herbal antifungal alkaloid berberine, in
Candida albicans. PLoS One. 9:e1045542014. View Article : Google Scholar : PubMed/NCBI
|
|
29
|
Wei GX, Xu X and Wu CD: In vitro synergism
between berberine and miconazole against planktonic and biofilm
Candida cultures. Arch Oral Biol. 56:565–572. 2011.
View Article : Google Scholar : PubMed/NCBI
|
|
30
|
Iwazaki RS, Endo EH, Ueda-Nakamura T,
Nakamura CV, Garcia LB and Filho BP: In vitro antifungal activity
of the berberine and its synergism with fluconazole. Antonie van
Leeuwenhoek. 97:201–205. 2010. View Article : Google Scholar : PubMed/NCBI
|
|
31
|
Quan H, Cao YY, Xu Z, Zhao JX, Gao PH, Qin
XF and Jiang YY: Potent in vitro synergism of fluconazole and
berberine chloride against clinical isolates of Candida
albicans resistant to fluconazole. Antimicrob Agents Chemother.
50:1096–1099. 2006. View Article : Google Scholar : PubMed/NCBI
|
|
32
|
Li DD, Xu Y, Zhang DZ, Quan H, Mylonakis
E, Hu DD, Li MB, Zhao LX, Zhu LH, Wang Y, et al: Fluconazole
assists berberine to kill fluconazole-resistant Candida
albicans. Antimicrob Agents Chemother. 57:6016–6027. 2013.
View Article : Google Scholar : PubMed/NCBI
|